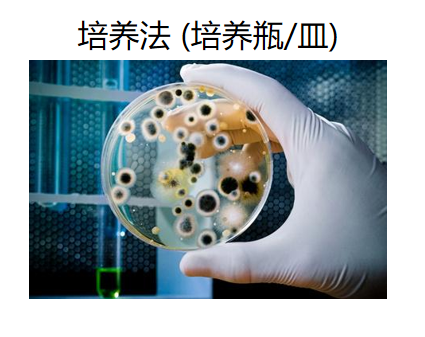

在与微生物交锋的战场上,时间,永远是决定胜负的关键。无论是医院里亟待确诊的感染病患,还是食品加工车间里潜在的污染风险,我们都渴望一个“超能力”——在最短的时间内,精准锁定目标微生物。然而,经典的微生物鉴定方法,如沿用了一个多世纪的平板划线培养,动辄需要数天才能给出答案。这个漫长的“时间窗口”足以让病情恶化,或让受污染的产品流入市场。
现在,想象一下,一道激光闪过,短短几秒到几分钟,电脑屏幕上就清晰地勾勒出目标微生物的“身份画像”。这听起来如同科幻电影里的场景,正在被拉曼光谱(Raman Spectroscopy)技术变为现实。这项技术正以其惊人的速度,引领着微生物鉴定领域告别传统的“培养皿时代”,迈入全新的“读秒时代”。
它正凭借其独特优势,在多个高频场景中展现出决定性的作用:
快速病原鉴定与药敏测试:在临床一线,它可以在数小时内判断出病原菌对抗生素的反应,为危重病人争取宝贵的治疗时间。
环境与工业微生物监测:它能像“星探”一样,从成千上万的微生物中,将那些具有特定功能(如降解塑料、产生抗生素)的“明星菌株”高效地筛选出来。
细胞表型与代谢追踪:它还可以在不破坏细胞的前提下,实时、动态地跟踪微生物的应激反应、芽孢萌发等生命过程,为基础研究提供了前所未有的强大新工具。
要理解拉曼光谱为何能做到这一切,我们需要深入到细胞的分子层面,去探寻它是如何构成并解码微生物“指纹”的。
传统鉴定流程通常需要经过耗时的培养、分离、纯化等步骤;而拉曼光谱法则可以直接从样本(甚至单个菌落)出发,实现快速鉴定,极大地缩短了时间。

拉曼光谱之所以能成为微生物的“指纹”,是因为它能精确记录细胞内各种生物大分子的振动信息。对微生物而言,其身份信息就编码在这些分子的“峰组合”中:
蛋白质:其骨架成分苯丙氨酸(Phenylalanine)在约 1003 cm-1处有一个极其尖锐和稳定的峰,常被用作光谱的“锚点”。
核酸(DNA/RNA):磷酸二酯键的振动在约 782 cm-1 处产生特征峰,反映了遗传物质的信息。
脂质:细胞膜等结构中的 CH₂ 基团的弯曲振动会在约 1445 cm-1 处形成一个强峰,代表了细胞的边界。
色素:某些细菌会产生类胡萝卜素,它们在约 1156 cm-1和 1518 cm-1处有强烈的共振拉曼峰,这不仅能用于菌种鉴定,还能指示其特定的生理状态。
综述与大量实证研究均显示,一个典型的细菌平均光谱,能够同时清晰地看到来自蛋白质、脂质与核酸的主成分峰。正是这些可复现的“峰组合”,为我们进行物种分类、表型判别与代谢状态评估提供了坚实的基础[1]。

采集到的光谱数据本身只是一堆曲线,要将它们变成精准的诊断和分类结果,离不开强大的计算分析,特别是人工智能的加持。
光谱预处理与指纹库:首先,需要对原始光谱进行一系列“峰工程”操作,例如以1003 cm-1(苯丙氨酸)等稳健峰为锚点进行校准,再进行去背景、向量归一化等处理,消除仪器和环境噪声。然后,将处理后的高质量光谱存入数据库。
机器学习与深度学习:利用主成分分析(PCA)、线性判别分析(LDA)、支持向量机(SVM)等经典机器学习模型对光谱进行分类。近年来,卷积神经网络(CNN)等深度学习模型展现出更强大的能力,尤其是在处理真实世界中可能遇到的未知菌、混合样本(如空气中的微生物气溶胶)等复杂场景时,表现出更高的鲁棒性和准确性。
从需要数天等待的琼脂平板,到只需几秒闪烁的激光,拉曼光谱正在以前所未有的速度、深度和精度,刷新我们对微生物世界的认知和掌控能力。它不仅仅是一项更快的鉴定技术,更是一个能够深入到单细胞和分子层面的强大洞察工具。微生物鉴定的“读秒”时代,已经到来。
[1] Cui, L., et al. (2020). Rapid identification of pathogenic bacteria using Raman spectroscopy and a deep learning-based model. Frontiers in Microbiology, 11, 874.
[2] Wang, C., et al. (2020). Rapidly monitoring the responses of single bacterial cells to antibiotic treatment with Raman spectroscopy. Analytical Chemistry, 92(15), 10428–10435.
[3] Ho, C. S., et al. (2021). Raman-based spectroscopy for pathogen diagnostics. Journal of Nanobiotechnology, 19(1), 63.